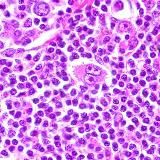
Лимфома Ходжкина

- Borsa
- Sandbox
- Eliminato
- GIF e Video869
- IT835
- SMM7134
- Telegram8282
- Auto e moto6243
- Blog d'autore2916
- Giochi d'azzardo582
- Barzellette152
- Anime798
- Agenda224
- Affari e finanza16642
- Blogger32604
- Militare256
- Miscellanea10420
- Oroscopi ed esoterismo5983
- Darknet757
- Design5735
- Per adulti2428
- Per uomini600
- Per i genitori5848
- Esami e prove8947
- Salute8744
- Giochi15929
- Instagram1919
- Arte5977
- Catalogo228
- Coronavirus233
- Красота и мода19039
- Criptovalute15501
- Cucina8446
- Trucchi200
- Linguistica3781
- Letteratura7381
- Negozi e vendite16521
- Medicina6484
- Mobile1624
- Musica16077
- Scienza e tecnologia10101
- Immobiliare1726
- Notizie39177
- Educazione14597
- Una riga146
- Podcast155
- Sentito di nascosto200
- Educativo1479
- Politica15295
- Contenuti per adulti 18+24043
- Natura e Animali5793
- Previsioni e scommesse9678
- Proxy40
- Psicologia13416
- Viaggi11162
- Varie173021
- Regionali1697
- Religione9868
- Fai-da-te2228
- Servizi162
- Fughe di notizie606
- Software196
- Sport10339
- Stickers190
- Costruzione e riparazione4900
- Lavoro remoto7027
- FEM-BLM164
- Fatti868
- Film e Serie TV11616
- Foto10823
- Offerte e sconti1461
- Citazioni8711
- Chat67649
- Contenuto scioccante1674
- Ecologia117
- Economia9334
- Umorismo14304
- Giurisprudenza2807
- 🇦🇲 Canali armeni203
- 🇦🇿 Canali azeri206
- 🇧🇾 Canali bielorussi992
- 🇬🇪 Canali georgiani47
- 🇰🇬 Canali kirghisi608
- 🇰🇿 Canali kazaki713
- 🇲🇩 Canali moldavi48
- 🇹🇯 Canali tagiki632
- 🇺🇦 Canali ucraini16424
- 🇺🇿 Canali uzbeki8953
Canali Telegram nella categoria «Varie»

Come cercare canali su TgramSearch
Poiché la ricerca dall'applicazione Telegram restituisce un numero limitato di risposte, è più conveniente utilizzare soluzioni di terze parti per cercare i canali Telegram.
TgramSearch consente di cercare in un database che contiene oltre 700.000 canali Telegram e, soprattutto, di ottenere un elenco completo di canali che soddisfano la tua richiesta.
L'elenco dei canali Telegram nel nostro database viene costantemente aggiornato. Per la ricerca, puoi scegliere la categoria che ti interessa o inserire la tua richiesta nella barra di ricerca. Non consigliamo di inserire richieste troppo lunghe; la richiesta dovrebbe essere composta da una a tre parole, idealmente una parola.
Rimozione del canale dalla ricerca
Si prega di notare che il sito viene riempito automaticamente da fonti aperte e non memorizza informazioni sui canali Telegram ad eccezione del nome, descrizione, link e avatar. Se trovi un canale Telegram che viola i requisiti di legge, ti preghiamo di contattarci tramite i contatti indicati nel menu del sito. Dopo aver esaminato il reclamo, rimuoveremo quel canale Telegram dalla ricerca.



![🅳[o̲̅]🆅[e̲̅]🆁[e̲̅]🅽[n̲̅]🆈[e̲̅] 🅽[i̲̅]🆉🅷[n̲̅]🅸[y̲̅] 🆃[a̲̅]🅶[i̲̅]🅻](https://cdn1.tgramsearch.com/images/d/2/d297cb5af55801d152b0ca0c5ec7872a.jpg?v=1)














